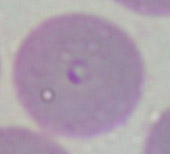
犬艾利西體 犬艾利西體

名詞概述
艾利希體是一種細小簡單的細菌歸類為立克次體類的病原體,它是藉由壁虱叮咬狗的皮膚之後,達到傳播目的的一種傳染病。在台灣,艾利希體是一種非常常見的傳染病,因為很多的畜主對艾利希體的傳染原-壁虱並沒有預防的觀念,所以在狗狗身上發現壁虱是常有的事情,畜主們也不以為然,認為如果發現壁虱時,把壁虱抓掉就好了,可是畜主們並不知道,這些不起眼的小蟲子,居然可以傳播一堆傳染病,嚴重的還會致命。
病理病徵
艾利希體在狗狗身上造成感染之後,會進入血液之中,寄生於白血球與血小板之中,當然這些艾利希體並不會這樣就算了,對血液系統的破壞才正要開始。感染艾利希體的狗狗,早期並不容易發現有被感染的徵兆,常常可以看到的症狀也常和其它疾病的病症相似,這些症狀如:發燒、精神不好、一天到晚都在睡覺、食慾變差、體重變輕、甚至會嘔吐等等,看到這些症狀,很少有人會去懷疑有艾利希體的感染問題,但是當病情漸漸變得嚴重之後,連主人們也都可以發現狀況不太對竟了,莫名其妙的狗狗身上居然出現了一堆瘀血斑,走路居然一拐一拐的,身體會有水腫的狀況,眼睛結膜紅紅的(結膜炎),這時大部分的畜主們應該會把狗狗帶去醫院做檢查與治療,不過有些飼主還繼續在ㄠ,可能自認為家裡的狗狗打架受傷瘀血了,所以只要多多的休息,馬上就可以復原了,但是,ㄠ到最後狀況就變得非常嚴重了,狗狗全身的黏膜變得非常的蒼白(嚴重的貧血),可能吃個飯牙齦就血流不止(嚴重的血小板缺乏),或是莫名其妙的,狗狗突然就瞎了(眼內出血、眼底發炎、視網膜剝離),甚至還嚴重到有肝衰竭及腎衰竭的可能性。 當牛蜱傳播牛蜱熱後,會有8至20天潛伏期。
臨床症狀:
1.急性期 ─ 常見的病徵可能是抑鬱、無精神、厭食、體重減輕、發燒及因肺出血而呼吸困難,大約40%犬只在急性期都發現牛蜱。臨床症狀可能未經治療而不再呈現,但犬只還是受感染進入另外一個階段。會維持2至4星期。艾利希體感染白血球細胞及製造和儲藏白血球的器官。包括脾臟、肝臟、淋巴腺及骨髓。感染後常導致器官發大,在嚴重情況下器官出現炎症及衰竭。它還降低血小板生存時間令到血液凝結所需的血小板數量減少及出血機會更高。在顯微鏡檢查下可發現艾利希體在白血球中,但對抗這感染的抗體需時間產生。
2.不完全病徵期 ─ 可能無任何臨床症狀。不完全病徵期會維持6至9星期,這段期間抗體反應會增加,而血液可出現與急性期同樣的轉變。不過臨床病徵可能很輕微或不嚴重。
3.慢性期 ─ 有些犬只可能輕微受影響,一些可能出現嚴重併發症包括:精神不振、體重減輕、蒼白、出血及足肢水腫。這階段通常並無牛蜱發現。50%受感染犬只出血機會增加而在嚴重出血情況下動物可出現休克。如嚴重出血發生在視網膜及腦部可導致失明及腦神經症狀。它和關節炎及關節出血引致跛行亦有關係。因無效的免疫反性產生而加重感染。白血球和紅血球製造會因骨髓受損而產量進一步減少。在這期間,抗體水平通常很高。
檢查治療
如何判症
只有50%受感染犬只有出血傾向,所以缺乏出血現狀不能排除艾利希體的可能性。有些受感染犬只可能出現非典型病徵,所以臨床症狀應跟其他血液測試一同考慮。要檢查是否有艾利希體事實上非常的簡單,只要每半年一次到醫院定期接受艾利希體的抽血檢驗,不到十分鐘,就可以知道檢查的結果。
血液測試 ─ 感染艾利希體的犬只在整個過程中,很大部份的血小板及白血球數量會減少及貧血。肝酵素活動程度可能因缺水及肝臟受損而減低。當肝受損,蛋白質會流失在尿液中而減低血蛋白質水平而導致體重減輕。
當然除了定期檢查之外,也要同時預防愛利希體的感染,艾利希體主要是由壁虱傳播的傳染病,有的文獻報告也指出,艾利希體也可能會藉由跳蚤與蚊子來傳播,既然主要的傳染原是壁虱,那么對壁虱的預防更是重要了,您只要每個月使用驅殺壁虱的藥劑,就可以預防家中的狗狗壁虱上身,感染艾利希體。
周邊血液
片檢查 ─ 從犬只周邊循環系統(如耳朵)採取一滴血液,將片染色及進行顯微鏡檢查。在急性期可以在白血球細胞中發現艾利希體。亦可出現在骨髓、肺部、肝臟、淋巴結及脾臟細胞。
抗體測試 ─ 這是大部份較準確地測試艾利希體。這測試敏感度高及特別針對艾利希體,而只需10分鐘便有結果。在急性期測試可能因為抗體需時才能產生所以出現假陰性結果。
目前的檢驗模組除了可以檢查出艾利希體外,更可以同時檢查心絲蟲與萊姆病這兩種傳染病,想想您家中的狗寶貝有沒有定期接受這種檢驗呢,若沒有,趕緊帶它去檢查吧!
治療方法
藥物殺死艾利希體及支援性治療,Tetracycline是一類常用的抗生素。它很安全及有效地消除艾利希體,但它可使生長中的牙齒變黃,所以不建議用於5個月大以下的犬只。Chloramphenicol是另一有效抗生素而能用於少於5個月大的幼犬。它亦是用於Tetracycline出現抗藥性時用的,有些用來殺掉焦蟲的藥物同樣有效地對付艾利希體。除了用抗生素,亦可能需要支援治療,尤其當動物有缺水情況。當白血球數量減小及骨髓生產受壓時,使用類固醇藥剌激骨髓可能有幫助。當血小板嚴重缺乏及出現多發性關節炎時,有時需要使用短期的免疫系統壓抑藥物。
如何預防
主要預防方法是防止牛蜱叮咬犬只。所有損血者亦要接受牛蜱熱測試,因它能經血液傳播。香港市面上有不同產品用來預防牛蜱。這些包括移除牛蜱,驅除牛蜱及殺除牛蜱的產品。